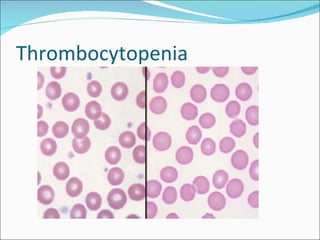
Thrombocytopenia
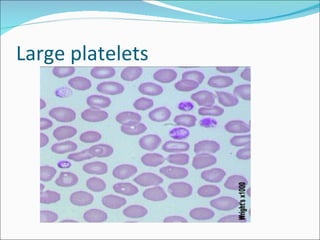
Large platelets
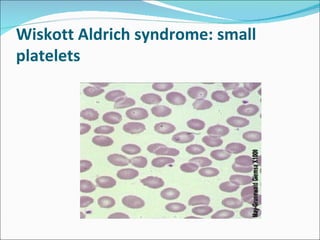
Wiskott Aldrich syndrome: small
platelets

This document discusses thrombocytopenia in neonates. It defines normal platelet counts and classifies thrombocytopenia based on etiology and clinical features. The main causes discussed are impaired platelet production, increased platelet consumption, and combined mechanisms. It provides details on epidemiology, specific conditions like neonatal alloimmune thrombocytopenia, evaluation, and treatment approaches for neonates with thrombocytopenia. Microscopic slides of normal and abnormal platelets are also included.